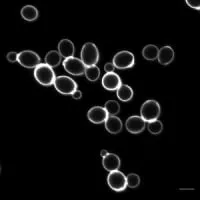

Saccharomyces
| Use attributes for filter ! | |
| Class | Saccharomycetes |
|---|---|
| Kingdom | Fungi |
| Order | Saccharomycetales |
| Scientific name | Saccharomyces |
| Rank | Genus |
| Higher classification | Saccharomycetaceae |
| Date of Reg. | |
| Date of Upd. | |
| ID | 951993 |
About Saccharomyces
Saccharomyces is a genus of fungi that includes many species of yeasts. Saccharomyces is from Greek σάκχαρον and μύκης and means sugar fungus. Many members of this genus are considered very important in food production. It is known as the brewer's yeast or baker's yeast. They are unicellular and saprophytic fungi.